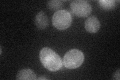
YIL121W
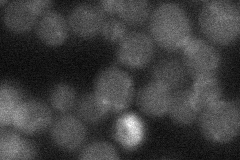
YIL121W
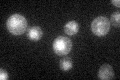
YIL121W

View description
Multidrug transporter of the major facilitator superfamily, required for resistance to quinidine, barban, cisplatin, and bleomycin; may have a role in potassium uptake
Localization:
Intensity:
Fold change:
Significance:
-
C’ GFP library in SD
cell periphery28.44 -
N' NOP1pr-GFP in SD

cell periphery51.7206 -
N' TEF2pr-mCherry in SD

cell periphery,vacuole113.532 -
N' NATIVEpr-GFP in SD
below threshold22.8741 -
N' TEF2pr-VC and Cyto-VN in SD

#N/A0 -
C’ GFP library in SD+DTT

cell periphery24.020.84No -
C’ GFP library in SD+H2O2

cell periphery28.340.99No -
C’ GFP library in Starvation Media
vacuoleN/AN/AYes -
C’ GFP library on the background of Pup2-DaMP

cell periphery -
C’ GFP library on the background of CCT mutant

cell periphery22.46240.789556No
